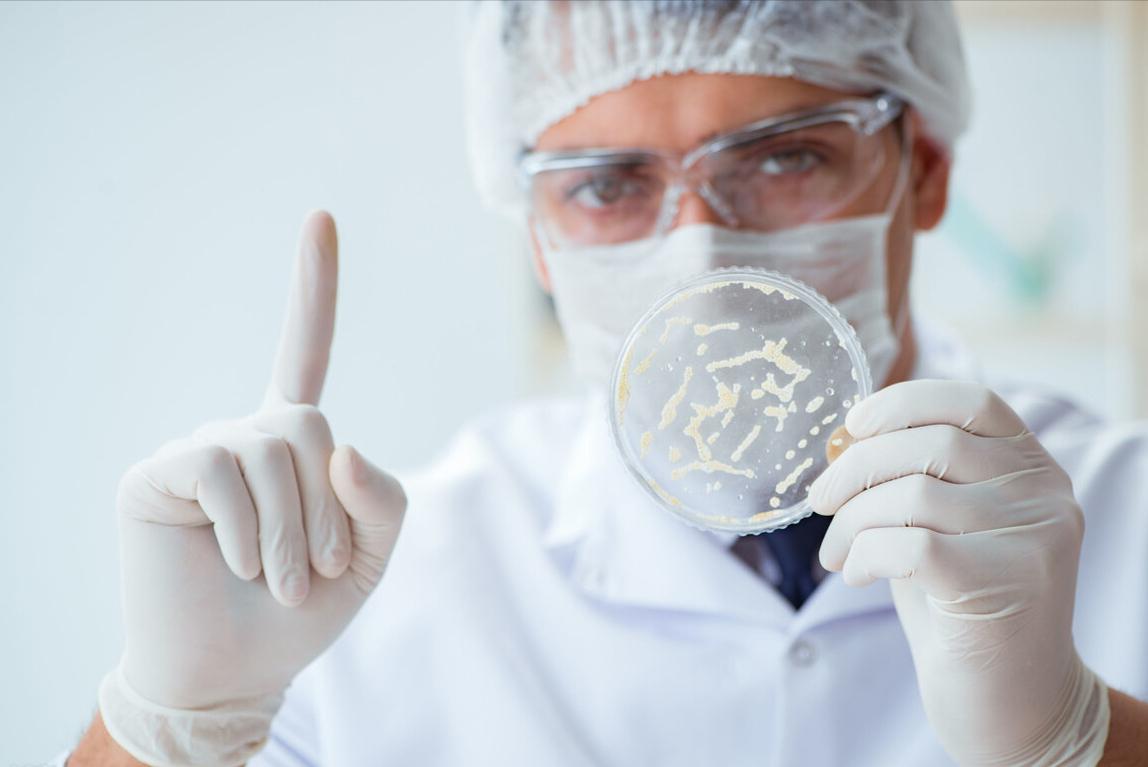
槟榔带来的危害,槟榔危害那么大为什么还有人吃

2021年8月12日,多名中国公民在入境土耳其时,因携带槟榔被捕,一时间槟郎又成了人们热议的话题。那么小小的槟郎为何被土耳其如此仇视?它到底有什么危害呢?

这些中国公民之所以会被捕,是因为在土耳其的法律里,槟郎因为具有致幻性而被认定为*品毒**。不仅土耳其如此,新加坡、阿联酋、加拿大和澳大利亚等国,同样将槟榔视为*品毒**,而美国甚至从1976年开始就禁止榔果的买卖。
[微风]槟榔到底有多大危害呢?
槟榔属于热带雨林作物,原产自马来西亚,主要分布在东南亚、亚洲热带地区、东非及欧洲部分区域,我国的槟榔则主要分布于云南、海南等地。

说起吃槟郎的历史,《史记》就有汉武帝兵征南越,并以槟榔解军中瘴疠的记载,乾隆皇帝手中价值连城的波斯手工和田玉罐就是为了装槟榔的。

如今市面上卖的槟郎,是将新鲜的槟郎果分成两半,然后去除果核晒干,加上荖花包裹的石灰,再经过炮制、切片、点卤、干燥等处理。在中国嚼槟榔主要流行于台湾、湖南、海南、福建等地。


[微风]槟榔为一级致癌物
早在2003年,世界卫生组织下属的国际癌症研究中心就已经将槟榔认定为一级致癌物,这并非是一种空穴来风的推断,2011年《中华口腔医学研究杂志》发表研究称,越流行嚼槟榔的国家和地区,口腔癌的发病率越高。
世界上槟榔消耗量最大的印度,口腔癌发病率居世界第一位,巴布亚新几内亚接近60%的居民咀嚼槟榔,口腔癌的发病率位居世界第二。而流行咀嚼槟榔的台湾,每10万男性居民中就有27.4例口腔癌患者。

通过对152位咀嚼槟榔者和137位不咀嚼槟榔者进行研究分析,我们发现84.4%咀嚼槟榔者患有口腔粘膜病变,而不咀嚼槟榔者的病变率仅有37.2%,同时咀嚼槟榔者的口腔粘膜病变中有超过20%为癌前病变,这些病变有很大的可能性恶变成口腔癌。

[微风]槟榔为什么会导致口腔癌呢?
咀嚼槟榔时,槟榔纤维会与口腔黏膜互相摩擦造成口腔粘膜的局部外伤和粘膜损伤,长期咀嚼槟榔就会导致损伤无法愈合,从而引起慢性炎症和损伤部位细胞增殖。

其次,槟榔含有大量生物碱,其中槟榔碱的重量达到了干槟榔净重的1%,这种碱能促进上皮细胞的凋亡,并阻碍胶原、弹性蛋白等大分子的沉淀和降解。槟榔外面包裹的荖花和石灰也有一定的生物毒性,倘若长期嚼槟榔,牙齿的磨耗严重,最终会导致牙齿变红或变黑甚至提前掉牙。

除了对牙齿产生危害,槟榔还会损害味觉神经与唾液分泌功能。2021年9月17日,中国国家广播电视总局下发通知,要求停止利用广播电视和网络视听节目宣传推销槟榔及其制品 ,怂叔在这里呼吁大家珍爱口腔健康 远离槟榔。